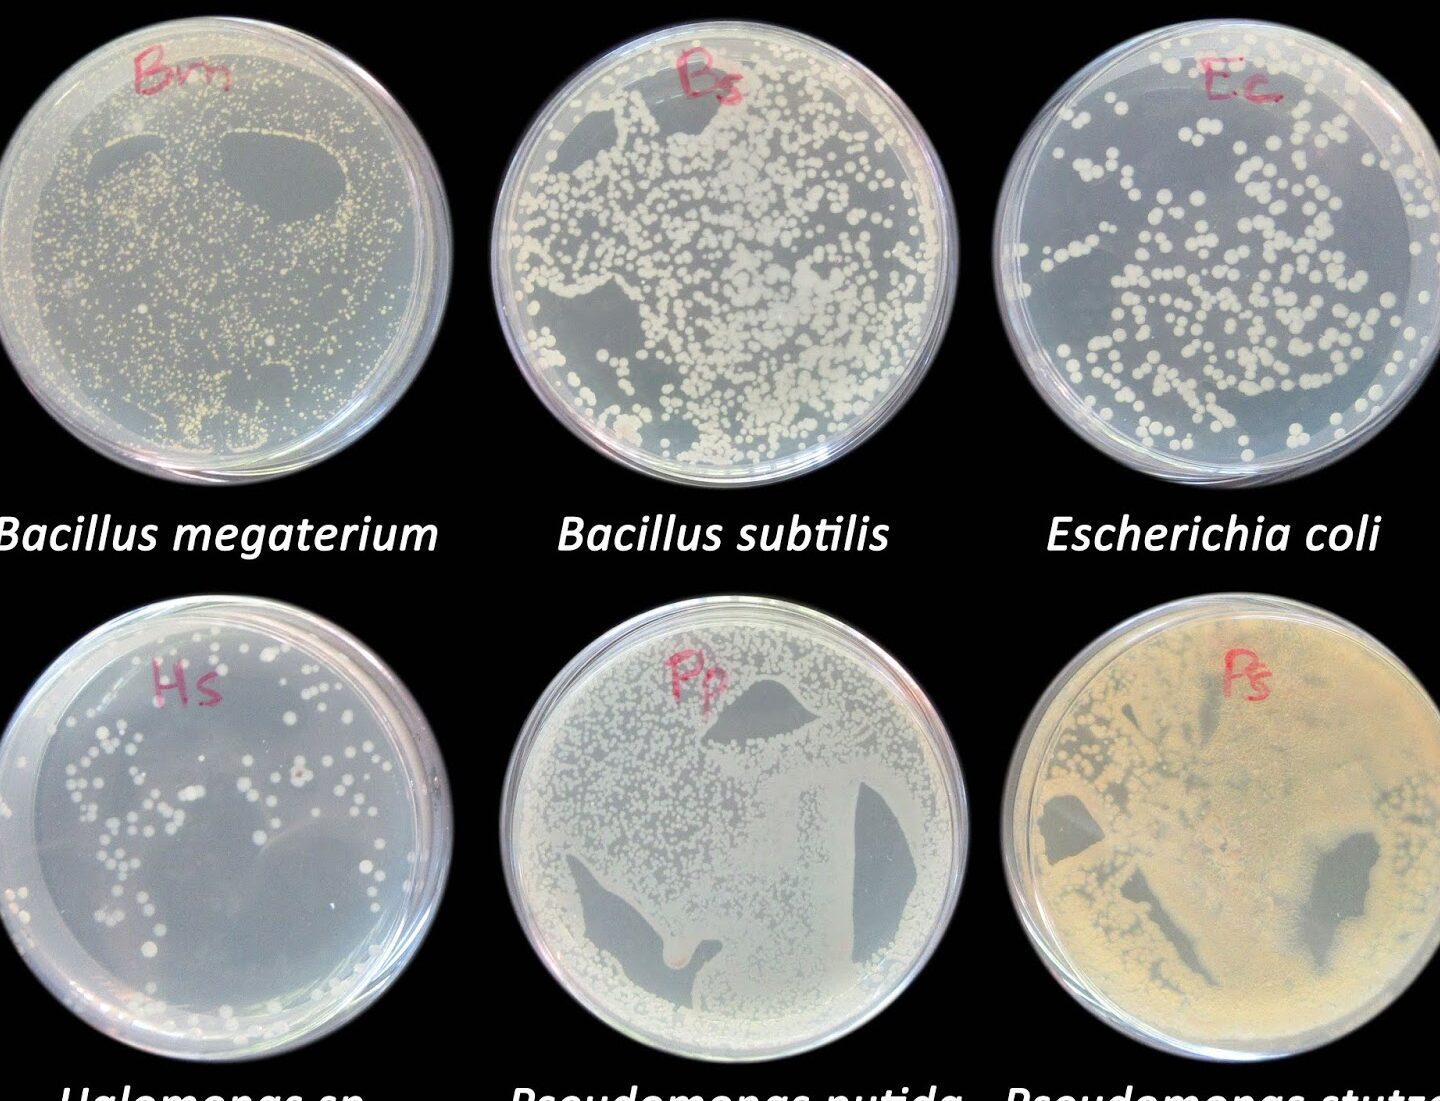

¿Sabías que las bacterias tienen una temperatura óptima para crecer y reproducirse de manera eficiente? La temperatura es un factor crucial para el crecimiento bacteriano y puede variar dependiendo del tipo de bacteria y del entorno en el que se encuentren. En este artículo, exploraremos en detalle qué es la temperatura óptima para el crecimiento de las bacterias, los factores que la afectan, la importancia de conocerla, los métodos de determinación y las aplicaciones prácticas de este conocimiento.
¿Qué es la temperatura óptima para el crecimiento bacteriano?
La temperatura óptima para el crecimiento bacteriano se refiere a la temperatura en la que una bacteria puede crecer y reproducirse de manera más rápida y eficiente. Es la temperatura en la que se maximizan las reacciones metabólicas y se obtiene el mayor rendimiento de crecimiento. Cada tipo de bacteria tiene una temperatura óptima específica, que puede variar desde unos pocos grados Celsius hasta más de 100 grados Celsius en casos extremos.
Factores que afectan la temperatura óptima
1. Composición del medio de cultivo
La composición del medio de cultivo en el que se encuentran las bacterias puede influir en su temperatura óptima de crecimiento. Algunos medios de cultivo contienen nutrientes específicos que favorecen el crecimiento bacteriano a temperaturas más altas o más bajas. Por ejemplo, algunas bacterias termófilas, que crecen a altas temperaturas, requieren medios de cultivo ricos en azúcares y proteínas para obtener energía.
2. Tipo de bacteria
Cada tipo de bacteria tiene una temperatura óptima específica para su crecimiento. Algunas bacterias son psicrófilas, lo que significa que crecen mejor a temperaturas frías, mientras que otras son termófilas y se desarrollan mejor a altas temperaturas. Otros factores, como el pH y la presencia de inhibidores, también pueden influir en la temperatura óptima de crecimiento de una bacteria en particular.
3. pH del medio
El pH del medio de cultivo puede afectar la temperatura óptima para el crecimiento bacteriano. Algunas bacterias son más sensibles a cambios en el pH y pueden tener una temperatura óptima más estrecha en un rango de pH específico. Por ejemplo, algunas bacterias acidófilas tienen una temperatura óptima más alta en un pH ácido.
4. Presencia de inhibidores
La presencia de inhibidores en el medio de cultivo puede afectar la temperatura óptima para el crecimiento bacteriano. Algunos inhibidores, como los antibióticos, pueden interferir con las vías metabólicas de las bacterias y disminuir su capacidad de crecimiento. Esto puede resultar en una temperatura óptima más alta o más baja para el crecimiento bacteriano, dependiendo del tipo de inhibidor presente.
Importancia de conocer la temperatura óptima
Conocer la temperatura óptima para el crecimiento bacteriano es de vital importancia en diversos campos, como la microbiología, la industria alimentaria, la farmacéutica y la investigación científica. A continuación, se presentan algunas razones por las que es importante conocerla:
1. Mejorar el rendimiento de los cultivos bacterianos
Conocer la temperatura óptima para el crecimiento bacteriano permite optimizar las condiciones de cultivo y mejorar el rendimiento de los cultivos bacterianos. Al proporcionar a las bacterias el entorno adecuado, incluyendo la temperatura óptima, se puede promover un crecimiento más rápido y una mayor producción de biomasa. Esto es especialmente importante en la industria alimentaria y farmacéutica, donde se producen bacterias para su uso en la fabricación de alimentos, medicamentos y otros productos.
2. Evitar contaminaciones y pérdidas en la producción
Conocer la temperatura óptima para el crecimiento bacteriano también ayuda a prevenir contaminaciones y pérdidas en la producción. Si las bacterias se cultivan a temperaturas no óptimas, pueden crecer más lentamente o no crecer en absoluto, lo que puede dar lugar a productos de baja calidad o inutilizables. Esto puede tener consecuencias económicas significativas, especialmente en la industria alimentaria y farmacéutica, donde la calidad y la seguridad de los productos son fundamentales.
3. Optimizar la eficiencia de los procesos biotecnológicos
En el campo de la biotecnología, conocer la temperatura óptima para el crecimiento bacteriano es esencial para optimizar la eficiencia de los procesos. Al ajustar la temperatura a la óptima, se pueden maximizar las tasas de crecimiento y producción de compuestos de interés, como enzimas o productos químicos. Esto puede tener aplicaciones en la producción de biocombustibles, la síntesis de productos químicos y la ingeniería de proteínas, entre otros.
Métodos de determinación de la temperatura óptima
Existen varios métodos para determinar la temperatura óptima para el crecimiento bacteriano. A continuación, se presentan tres métodos comunes:
1. Método de crecimiento en placa
El método de crecimiento en placa consiste en sembrar una muestra de bacterias en diferentes placas de cultivo y incubarlas a diferentes temperaturas. Luego, se observa el crecimiento bacteriano en cada placa y se determina la temperatura a la que se produce el mejor crecimiento. Este método es simple y rápido, pero solo proporciona una estimación aproximada de la temperatura óptima.
2. Método de crecimiento en tubo
El método de crecimiento en tubo es similar al método de crecimiento en placa, pero se utiliza un tubo de ensayo en lugar de una placa de cultivo. Se siembran diferentes tubos de ensayo con bacterias y se incuba cada uno a una temperatura diferente. Luego, se observa el crecimiento bacteriano en cada tubo y se determina la temperatura óptima. Este método proporciona una estimación más precisa de la temperatura óptima que el método de crecimiento en placa.
3. Método espectrofotométrico
El método espectrofotométrico se basa en la medición de la turbidez de una muestra bacteriana a diferentes temperaturas utilizando un espectrofotómetro. Se registra la absorbancia de la muestra a diferentes longitudes de onda y se determina la temperatura a la que se produce la máxima absorbancia, que indica el mejor crecimiento bacteriano. Este método proporciona una estimación precisa de la temperatura óptima y es especialmente útil para bacterias que no forman colonias visibles en placas de cultivo.
Aplicaciones prácticas de conocer la temperatura óptima
Conocer la temperatura óptima para el crecimiento bacteriano tiene numerosas aplicaciones prácticas en diversos campos. A continuación, se presentan algunas aplicaciones destacadas:
1. Industria alimentaria
En la industria alimentaria, conocer la temperatura óptima para el crecimiento bacteriano es esencial para garantizar la seguridad y la calidad de los alimentos. Permite establecer las condiciones de procesamiento y almacenamiento adecuadas para prevenir el crecimiento de bacterias patógenas y la producción de toxinas. Por ejemplo, el conocimiento de la temperatura óptima para el crecimiento de la bacteria Listeria monocytogenes ha sido clave para el desarrollo de protocolos de seguridad alimentaria en la producción de alimentos listos para consumir.
2. Industria farmacéutica
En la industria farmacéutica, conocer la temperatura óptima para el crecimiento bacteriano es fundamental para la producción de antibióticos y otros medicamentos. Permite optimizar las condiciones de fermentación y garantizar la eficacia y la calidad de los productos finales. Por ejemplo, la bacteria Streptomyces, utilizada en la producción de la mayoría de los antibióticos, tiene una temperatura óptima de crecimiento alrededor de 30-37 grados Celsius.
3. Investigación científica
En la investigación científica, conocer la temperatura óptima para el crecimiento bacteriano es esencial para el estudio de la fisiología y el metabolismo de las bacterias. Permite establecer las condiciones de cultivo adecuadas para la realización de experimentos y la obtención de resultados fiables. Además, el conocimiento de la temperatura óptima puede ayudar a identificar y caracterizar nuevas especies bacterianas.
Preguntas frecuentes
1. ¿Qué sucede si la temperatura es demasiado baja para el crecimiento bacteriano?
Si la temperatura es demasiado baja para el crecimiento bacteriano, las bacterias pueden crecer más lentamente o no crecer en absoluto. Esto puede resultar en un rendimiento de crecimiento reducido y una producción más lenta de biomasa o productos metabólicos. Además, algunas bacterias pueden sufrir daños en sus estructuras celulares y funciones metabólicas si se exponen a temperaturas muy bajas durante períodos prolongados.
2. ¿Cuáles son los rangos de temperatura óptima para diferentes tipos de bacterias?
Los rangos de temperatura óptima para diferentes tipos de bacterias pueden variar ampliamente. Algunas bacterias psicrófilas tienen una temperatura óptima alrededor de 0-15 grados Celsius, mientras que algunas bacterias termófilas pueden tener una temperatura óptima por encima de 50 grados Celsius. Es importante tener en cuenta que estos rangos son solo aproximados y pueden variar dependiendo de las condiciones específicas de cultivo.
3. ¿Qué ocurre si la temperatura es demasiado alta para el crecimiento bacteriano?
Si la temperatura es demasiado alta para el crecimiento bacteriano, las bacterias pueden sufrir daños en sus estructuras celulares y funciones metabólicas. Esto puede resultar en una disminución del crecimiento y la producción de biomasa, e incluso en la muerte de las bacterias. Algunas bacterias termófilas pueden tolerar temperaturas más altas, pero también tienen límites de temperatura en los que su crecimiento se ve afectado negativamente.
4. ¿Cómo puedo determinar la temperatura óptima para una bacteria específica?
Para determinar la temperatura óptima para una bacteria específica, puedes utilizar alguno de los métodos mencionados anteriormente, como el método de crecimiento en placa, el método de crecimiento en tubo o el método espectrofotométrico. Si estás trabajando con una bacteria desconocida, puedes probar diferentes temperaturas de incubación y observar el crecimiento bacteriano en cada una. La temperatura a la que se obtiene el mejor crecimiento será la temperatura óptima para esa bacteria en particular.
Conclusión
Conocer la temperatura óptima para el crecimiento de las bacterias es esencial para optimizar el rendimiento de los cultivos bacterianos, prevenir contaminaciones y pérdidas en la producción, y optimizar la eficiencia de los procesos biotecnológicos. A través de diferentes métodos de determinación, como el crecimiento en placa, el crecimiento en tubo y el método espectrofotométrico, es posible conocer la temperatura óptima para una bacteria específica. Este conocimiento tiene aplicaciones prácticas en la industria alimentaria, la industria farmacéutica y la investigación científica. ¡No subestimes la importancia de la temperatura óptima para el crecimiento de las bacterias y asegúrate de tenerla en cuenta en tus estudios y procesos!
Ahora que sabes más sobre la temperatura óptima para el crecimiento de las bacterias, ¡te invitamos a explorar otros artículos relacionados con el fascinante mundo de la microbiología y la biotecnología!